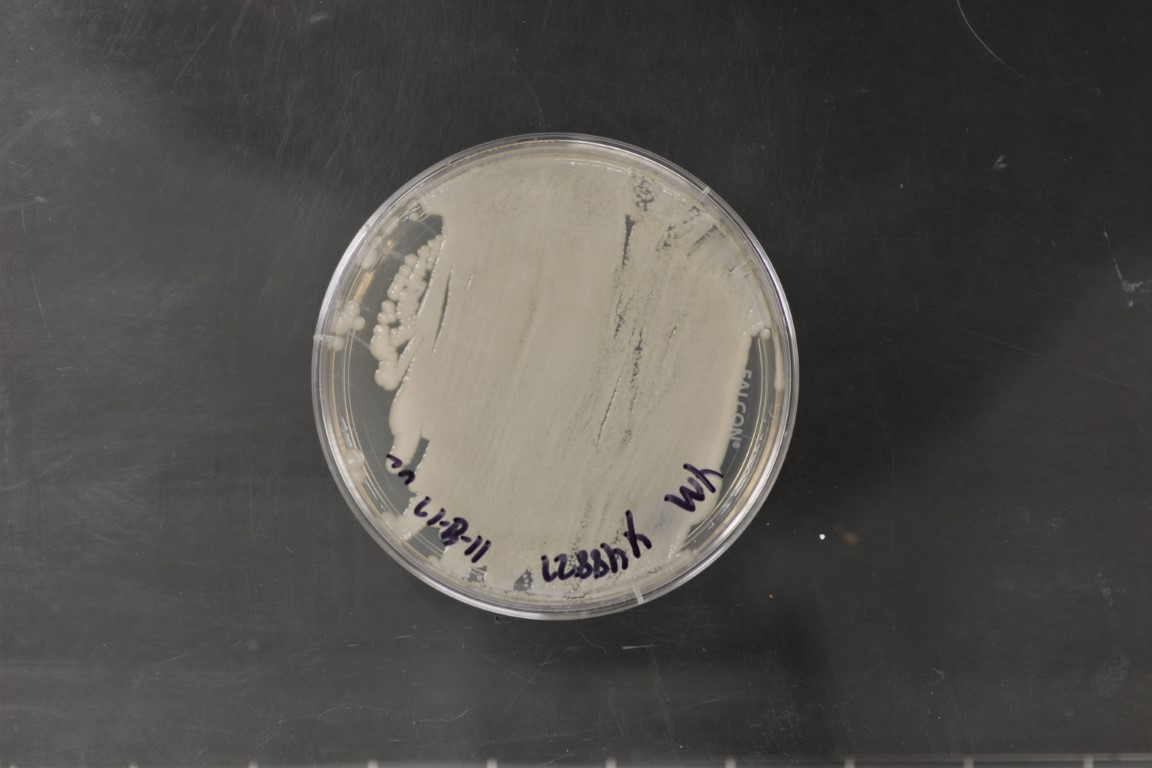

Scheffersomyces illinoinensis
NRRL Y-48827(Type Strain)
Accession numbers in other collections:CBS 12624=NBRC 112836=W07-11-15-9-2-1
Source:Meredith Blackwell,Louisiana State University,Baton Rouge,Louisiana
Isolated from(substrate):TR,rotten wood of Carya illinoinensis
Substrate location:810 Pecan Dr.,St.Gabriel,Ascension Parish,Louisiana,USA
Genetic info:GenBank:D1/D2(JN703959),SSU(JN940968),ITS(JN943261),LSU(JN703959),RPB1(JN804840),XYL1(JQ235694).
Growth media:Yeast Extract-Malt Extract-Peptone-Glucose(YM for yeasts)(number 6)
Optimum growth temperature:25C
Strain images:
NRRL_Y-48827_6.JPG

Comments:MycoBank number MB563457